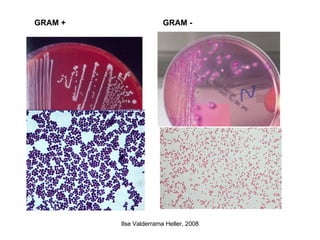
GRAM + GRAM -

Este documento trata sobre aspectos generales de microbiología clínica. Explica que la microbiología estudia los seres vivos no visibles a simple vista como bacterias, hongos, virus y parásitos. Describe las diferentes ramas de la microbiología y la diversidad microbiana, incluyendo los tipos celulares procariotas y eucariotas. También resume la clasificación de los organismos vivos y las características diferenciales entre bacterias, arqueas y eucariotas.